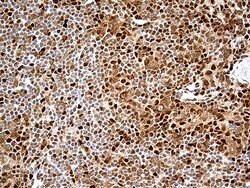
MTOR Monoclonal Antibody (OTI1C3), TrueMAB , OriGene 100 &mu;L; Unconjugated:Anticuerpos

missing translation for 'onlineSavingsMsg'
Learn More
Learn More
MTOR Monoclonal Antibody (OTI1C3), TrueMAB™, OriGene
Mouse Monoclonal Antibody
Marca: Origene Technologies TA805908

Este artículo no se puede devolver.
Vea la política de devoluciones
Descripción
Mammalian target of rapamycin (mTOR) is a serine/threonine kinase that plays a key role in cell growth, cell proliferation, and protein synthesis. mTOR mediates phosphoinositide 3-kinase and Akt/PKB signaling, resulting in phosphorylation of 4EBP1, and initiation of mRNA translation. A second pathway involves regulation of ribosomal S6 kinase, which affects ribosome biogenesis and translation elongation. Mutations affecting the gene results in Smith-Kingsmore syndrome.Especificaciones
| MTOR | |
| Monoclonal | |
| 1 mg/mL | |
| PBS with 1% BSA, 50% glycerol and 0.02% sodium azide | |
| P42345 | |
| MTOR | |
| Human recombit protein fragment corresponding to amino acids 1766-2144 of human MTOR produced in E.coli. | |
| 100 μL | |
| Primary | |
| Human | |
| Antibody | |
| IgG2a |
| Western Blot | |
| OTI1C3 | |
| Unconjugated | |
| MTOR | |
| FRAP, FRAP1, FRAP2, RAFT1, RAPT1, SKS | |
| Mouse | |
| Affinity Chromatography | |
| RUO | |
| 2475 | |
| -20° C, Avoid Freeze/Thaw Cycles | |
| Liquid |
Corrección del contenido de un producto
El Programa Encompass de Fisher Scientific ofrece artículos que no forman parte de nuestra cartera de distribución. Estos productos no suelen tener imágenes ni descripciones detalladas. Sin embargo, nos comprometemos a mejorar su experiencia de compra. Utilice el siguiente formulario para hacernos llegar sus comentarios sobre el contenido de este producto.
Título del producto
¿Detecta una oportunidad de mejora?Comparta una corrección de contenido